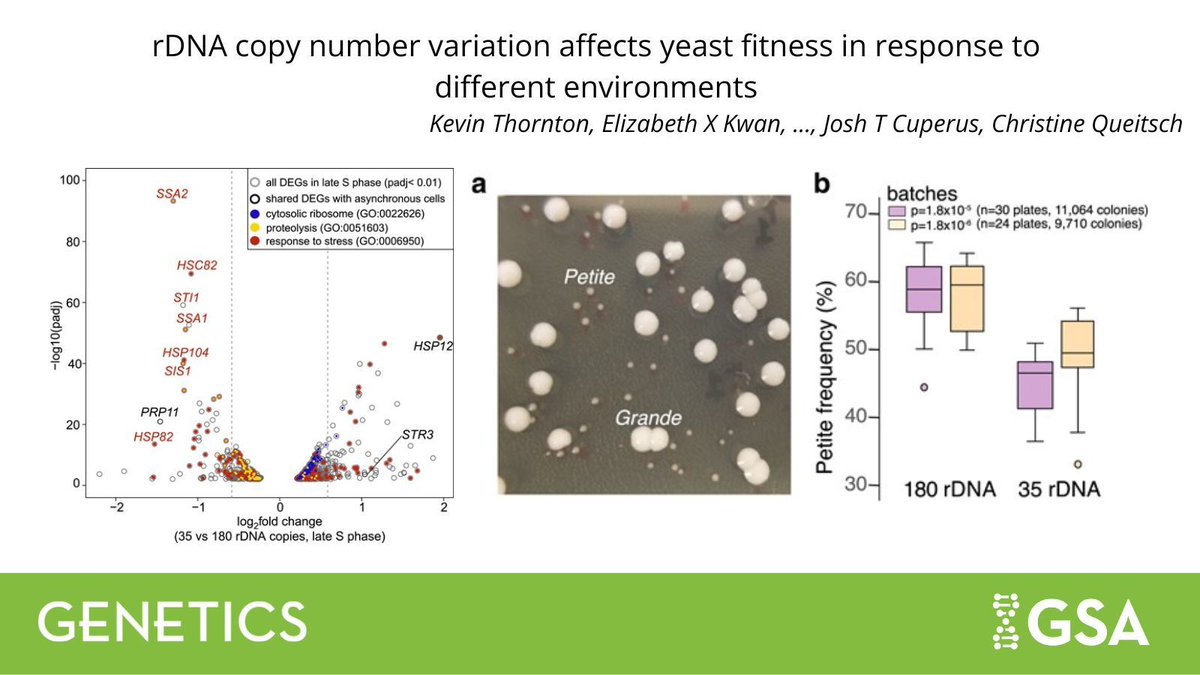
Genetics Society of America tweet media

Josh Cuperus retweetledi

Our lab's new paper is out!
We introduce ENTRAP-seq, a high-throughput in planta assay for multiplexed profiling of protein-coding libraries. Using ENTRAP-seq and machine learning, we discovered transcriptional regulators from ~1,500 plant viral genomes.
go.nature.com/4pw5cL1
English